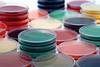
shutterstock_103464272

All Rapid Microbiological Methods (RMMs) articles
-
 News
NewsEnhanced fluorescence technique optimises bacterial detection
Study findings could improve fluorescence-based bacterial quantification.
-
 News
NewsNovel rapid microbiological detection method could advance surface monitoring
Innovative approach provides a promising alternative to culture-based methods for routine microbial surface monitoring.
-
 News
NewsDr Michael J. Miller joins Spore.Bio as VP of Scientific and Regulatory Affairs
The French start-up focuses on advancing rapid microbiology in manufacturing quality control.
-
 News
NewsPharmaLab previews new conference tracks ahead of 2025 Düsseldorf event
The pharmaceutical laboratory meeting adds sessions on AI in labs, and quality in biologics, mRNA and analytics.
-
 Article
ArticleEuropean Pharmaceutical Review Issue 3 2025
EPR Issue 3 includes articles on microbiology, downstream processing, manufacturing, drug formulation and more.
-
News
AI driving automated microbiological testing market growth to 2033
Regulatory pressures and demand for trained operators is expected to hinder growth of the rapid microbiological testing market into the next decade, research suggests.
-
 Article
ArticleInvesting in the future of pharmaceutical microbiology QC
Troy Wright, Senior Vice President and Global Head of Quality at Abzena, shares an overview of current major challenges within pharmaceutical microbiology quality control, including the lack of staff knowledge in advanced technologies and how the sector’s importance can be overlooked, despite its key role in bringing safe, quality products ...
-
 Whitepaper
WhitepaperApplication note: The need for rapid methods in the compounding pharmaceutical industry
This application note explores rapid microbial methods and balancing patient care, quality products, and safe shelf lives for unique formulations.
-
 News
NewsPharmaLab Congress 2024 - what’s new for the third year in Düsseldorf/Neuss
Find out what is on offer for pharma professionals working in analytical development and microbiology QC at the 12th PharmaLab Congress being held in Germany in 2024.
-
 News
NewsMicrobial contamination detection with rapid spectroscopy
The detection method was designed for continuous culture monitoring of cell therapy products and required minimal sample preparation, research showed.
-
 Whitepaper
WhitepaperAdvertorial: Next-generation microbial testing of pharmaceuticals
Specialised microbial testing is key in drug development to mitigate contamination risks, which threaten drug efficacy and patient safety. Bruker's MALDI Biotyper® at MPL, Austria, ensures accurate and robust testing, in a high-throughput workflow, delivering reproducible results.
-
 Whitepaper
WhitepaperApplication note: Automated nucleic acid amplification assay for mycoplasma detection in cell and gene therapy products
Ambili Menon, Pharma Quality Control, bioMérieux Inc. addresses the task of microbiological testing for advanced therapeutic medicinal products.
-
 Report
ReportPharma Horizons: Cell and Gene Therapy
This report is dedicated to exploring some of the latest innovations in the cell and gene therapy space, from development and quality control, through to manufacturing and clinical trials.
-
 Article
ArticleGuide to Testing 2024
In this Guide to Testing articles explore limit of detection requirements for microbial testing of short-shelf-life products and sustainable endotoxin testing.
-
 News
NewsEP monographs allow rFC for water testing
As of 1 April, two European Pharmacopoeia monographs allow the use of rFC to test for bacterial endotoxins in pharmaceutical waters.
-
 Report
ReportPharma Horizons: Environmental Monitoring
This report is dedicated to exploring some of the latest advances in pharmaceutical environmental monitoring, covering topics from contamination control and cleanroom validation through to emerging technologies for bacterial endotoxin testing.
-
News
NewsInnovative method could offer cost-effective sterilisation approach
The new sterilisation method could provide an affordable, rapid approach for preparing microbiological culture media, research suggests.
-
 News
NewsUSP recommends revisions to proposed RMM chapters
Revisions for two proposed USP chapters recommend changes for rapid tests required for releasing sterile short-life products, as well as for rapid microbiological methods (RMM) for detecting contamination in these products.
-
 Article
ArticleDeveloping micro QC for ATMPs
In this Q&A, Natalie Saunders, Interim Head of Quality Control at CGT Catapult, delves into the advancements and challenges in microbiological QC for cell and gene therapies. She discusses rapid sterility testing methods, regulatory frameworks, and the impact of automation and digitalisation on quality control.
-
 News
NewsInnovative technologies facilitate novel contamination-detection method
A new 24-hour sterility testing method combining nanopore sequencing and machine learning could revolutionise sterility assurance in biopharmaceutical manufacturing of cell therapies.



